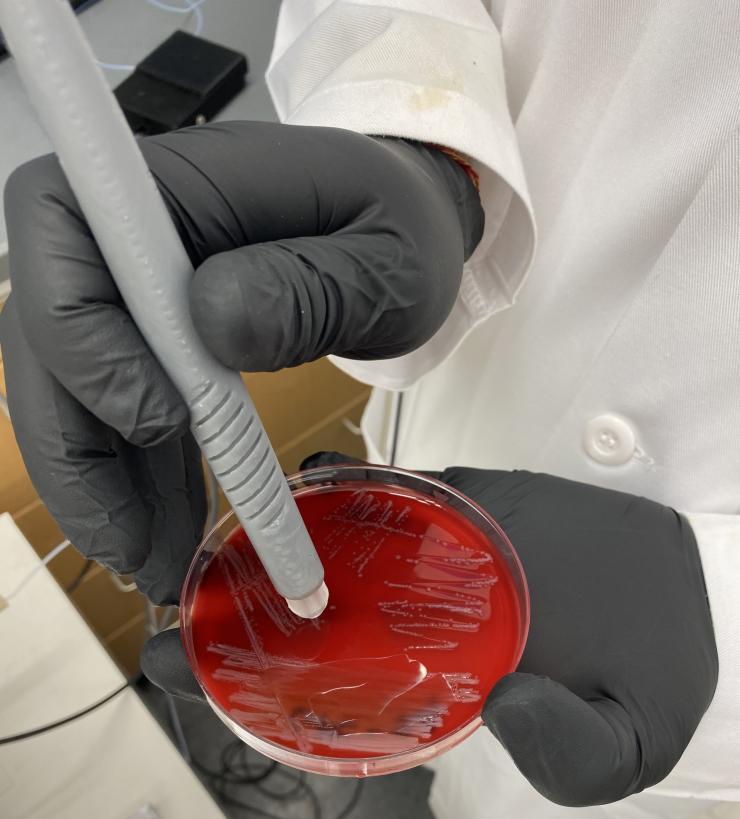
Identification of Infectious Diseases

Our laboratory is very interested in using our innovative technologies to provide new methods for rapid identification of infectious diseases. We are particularly interested in using the MasSpec Pen technology to look at molecular signatures of clinically relevant bacteria and identify markers to antibiotic resistant. We have a particular interest in clinically relevant projects in this area that have clear impact in patient care. For example, we have an ongoing NIH-funded project in which we are applying the MasSpec pen to identify pathogens and resistance in osteoarticular infection samples from pediatric patients. Our work in this field has the potential to allow rapid identification of bacteria and their resistance to improve patient care.








